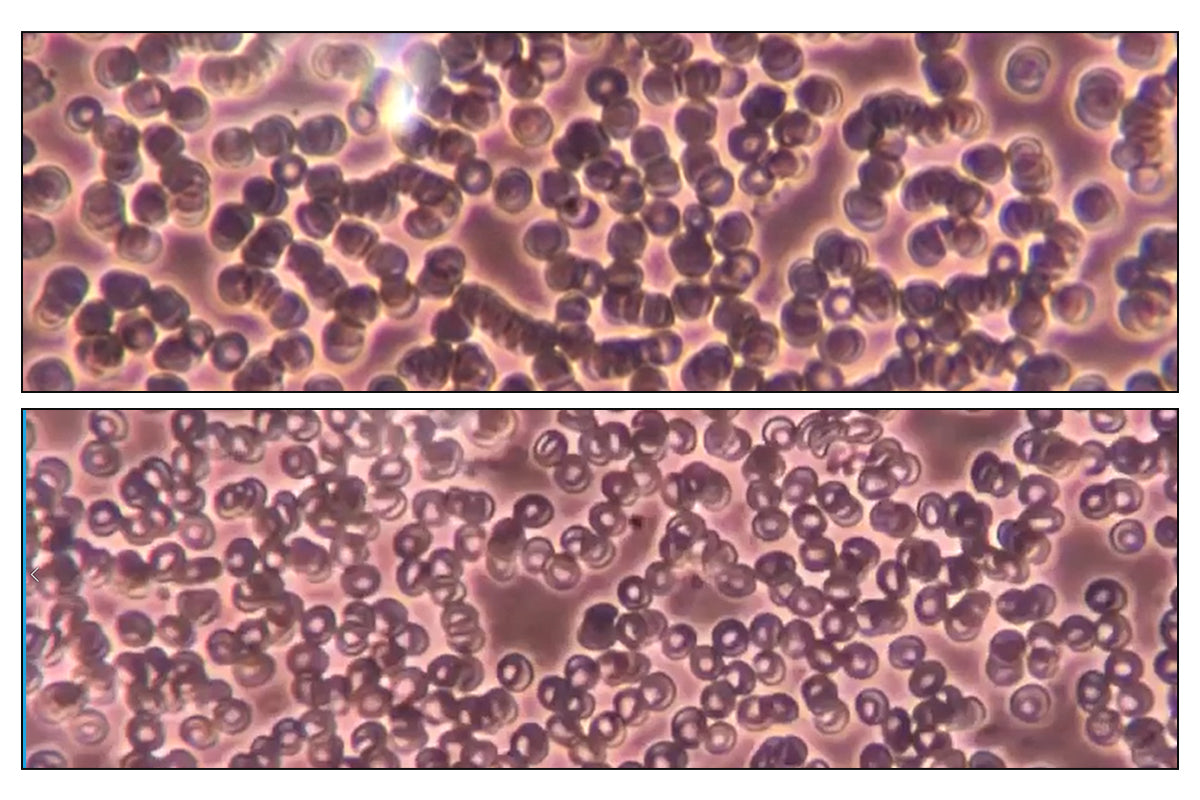

Clinical Basis No. 1:
the Benefits of Vibroacoustic Therapy Massage in Tension Headache and Neck Pain
Clinical Basis No. 2:
Effects of Vibroacoustic Therapy Massage on Blood Circulation
Clinical Basis No. 3:
Effects of Vibroacoustic Therapy Massage on Dermal Density
Clinical Basis No. 4:
Effects of Vibroacoustic Therapy Massage on Inflammation and the Immune System

Reduction of Cytokines
Human dermal fibroblasts induced with the pro-inflammatory metabolite arachidonic acid showed decreased IL-1β under vibroacoustic stimulation. (Reduction of IL-1β indicates decreased inflammation.)By reducing inflammation, this approach may help alleviate pain and related symptoms.
Clinical Basis No. 5:
Effects of Vibroacoustic Therapy Massage on Cellular Regeneration

Mitochondrial Activation Concentration Comparison Test
Direct energy transfer triggers bodily energy metabolism. By activating mitochondria, it actively promotes cell regeneration and recovery. In cells induced with inflammation, activation increased by more than threefold. This stimulates body metabolism and represents a key factor in cell regeneration.
Clinical Report

Drspa Personal Clinical Report on Vibroaccoustic Therapy Massage for Hair
The treatment demonstrates comprehensive benefits for scalp and hair health, including enhanced cleansing efficacy, improved scalp blood circulation, effective keratin management, balanced sebum regulation, increased hair moisturization, improved hair volume, stimulated new hair growth, and enhanced hair elasticity.